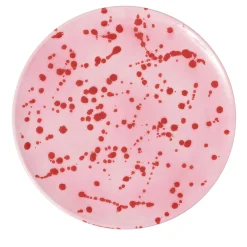

Sale!
Original price was: €212.52.€116.74Current price is: €116.74.
€122.35
Sale!
Original price was: €540.04.€114.90Current price is: €114.90.
€118.58
Sale!
Original price was: €519.80.€122.26Current price is: €122.26.
€109.38
Sale!
Original price was: €165.60.€109.38Current price is: €109.38.
Sale!
Original price was: €165.60.€109.47Current price is: €109.47.
€108.55
€124.10
Sale!
Original price was: €108.56.€73.50Current price is: €73.50.